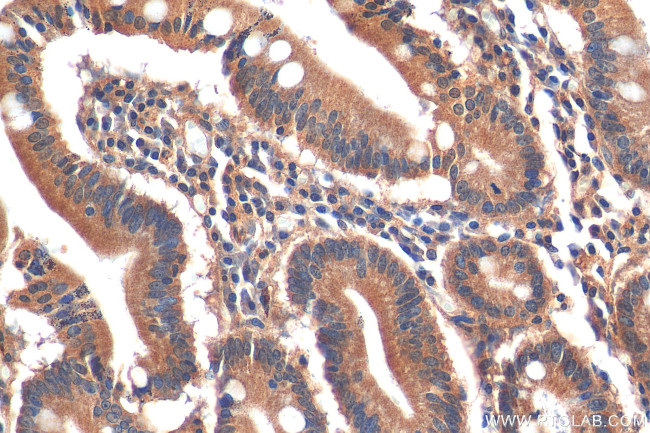
C19orf45 Antibody in Immunohistochemistry (Paraffin) (IHC (P))

Search
Proteintech
C19orf45 Polyclonal Antibody
{{$productOrderCtrl.translations['antibody.pdp.commerceCard.promotion.promotions']}}
{{$productOrderCtrl.translations['antibody.pdp.commerceCard.promotion.viewpromo']}}
{{$productOrderCtrl.translations['antibody.pdp.commerceCard.promotion.promocode']}}: {{promo.promoCode}} {{promo.promoTitle}} {{promo.promoDescription}}. {{$productOrderCtrl.translations['antibody.pdp.commerceCard.promotion.learnmore']}}
产品信息
21060-1-AP
种属反应
宿主/亚型
分类
类型
抗原
偶联物
形式
浓度
规格
纯化类型
保存液
内含物
保存条件
运输条件
产品详细信息
Immunogen sequence: SLPPGDRDKL RIPPTTHQAL FPPHDARPQP RAPSCHLGGP NTLKWDYTRQ DGTSYQRQFQ ALPGPPALRC KRASSGVELG DCKISYGSTC SEQKQAYRPQ DLPEDRYDKA QATAHIHCVN IRPGDGLFRD RTTKAEHFYA REPEPFVLHH DQTPESHILK GNWCPGPGSL DTFMQYFYGQ PPPPTQPPSR HVPHEKLQSH VTLGEPKLLK RFFKTTMGSD YCPSEWRQVQ KAPNLHLQQS YLPRGTGEFD FLTMNQKMLK PHRTPPAPVT EEMLQRCKYS HMEPPLGGLR FFSTQYKDEF PFKYQGPAAL RLKNPQEGFV PLGTPHQRGC REKIDPLVPQ PPMYLCPSQQ
靶标信息
TEX45 is a protein coding gene.
仅用于科研。不用于诊断过程。未经明确授权不得转售。
篇参考文献 (0)
生物信息学
蛋白别名: Stabilizer of axonemal microtubules 5; testis expressed 45; Testis-expressed protein 45; uncharacterized protein C19orf45; unnamed protein product
基因别名: C19orf45; SAXO5; TEX45
UniProt ID: (Human) Q8NA69
Entrez Gene ID: (Human) 374877